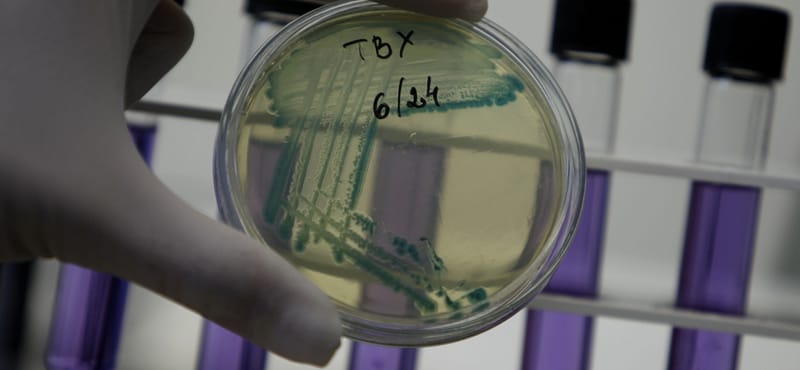

Most Franciaországban tört ki a hasmenésjárvány
A francia egészségügyi hatóságok azt már megállapították, hogy a megbetegedéseknek nincsen köze a múlt héten Lille-ben...
A francia egészségügyi hatóságok azt már megállapították, hogy a megbetegedéseknek nincsen köze a múlt héten Lille-ben történt kollektív ételmérgezésnek, amikor nyolc gyermek a Lidl diszkontáruházban forgalmazott fagyasztott húspogácsától fertőződött meg a különleges kóli bélbaktériummal. A mostani fertőzés pontos okát és a baktérium eredetét még vizsgálják. Három, súlyos állapotba került 41 és 65 év közötti nőt akut veseelégtelenséggel a bordeaux-i egyetemi kórház intenzív osztályán kezelnek, mindhárman dialízisre szorulnak.
Két másik beteget, egy 35 éves férfit és egy 47 éves nőt a helyi katonai kórház belgyógyászatán ápolják antibiotikumokkal, az ő állapotuk folyamatosan javul. Két másik személyt, akik csütörtökön kerültek kórházba, péntek délelőtt már hazaengedtek az orvosok. Az összes beteg Bordeaux vonzáskörzetében él, ketten Begles, a többiek pedig Talence településen, de a súlyos hasmenéses megbetegedésen kívül nincs köztük semmilyen kapcsolat, nem ismerik egymást.

Az öt kevésbé súlyos állapotban lévő beteget ellátó orvos, Patrick Gergoy a France 2 közszolgálati televízió híradójának elmondta: egyelőre még keresik a közös kapcsolatot a betegek között, s azt feltételezik, hogy a fertőzésnek élelmezéssel kapcsolatos eredete lehet. Ugyanakkor azt is vizsgálják, hogy a betegek esetleg fürödtek-e az elmúlt napokban a tengerben vagy pedig jártak-e ugyanazon a helyen. Az ivóvíz-ellátórendszert a járványügyi hatóságok már ellenőrizték, s a vizsgálatok során ott nem találták nyomát kóli baktériumnak.